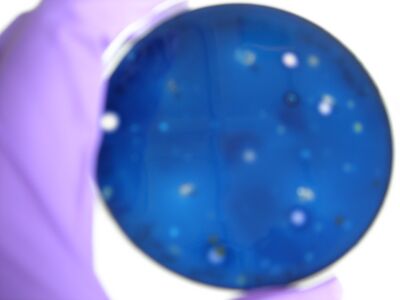

IGEM:Cambridge/2008/Turing Pattern Formation/Experiments/Bacillus subtilis transfomation
Transformation of Bacillus Subtilis
Our aim
We want to transform Bacillus Subtilis with two kinds of vectors: episomal vectors and integration vector. We would like to obtain good efficiency, no contamination and some precise tests confirm our transformations and to be able to standardize our protocol
Material
- 3 different strains:
- IA1
- IA751
- IA771 which contains erm insertion at the amyE locus, so transformants at the amyE locus can be screened for erythromycin resistance
- 15 different vectors which have been gel-tested (correct size achieved with double digests)
- 10 integration vectors (7 validated)
- 5 shuttle vectors (3 validated)
Media Preparation
- 10X Medium A base:
- Yeast extract 10g
- Casamino acids 2g
- Distilled water to 900mL
- Autoclave, then add :
- 50% glucose, filter sterilized 100mL
- 10X Bacillus salts:
- (NH4)2SO4 20g
- Anhydrous K2HPO4 139.7g
- KH2PO4 60g
- Tri-sodium citrate 10g
- MgSO4•7H2O 2g
- SDW to 1000mL
- Medium A
- Sterile water 81mL
- 10X Medium A base 10mL
- 10X Bacillus salts 9mL
- L-Tryptophan (11mg/mL) 0.1mL
- Medium B
- Medium A 10mL
- 50mM CaCl2•2H2O 0.1mL
- 250nM MgCl2•6H2O 0.1mL
Important:
- Autoclave Medium A base before adding glucose, and autoclave Bacillus salts
- Store aliquots of 10X Medium A base 10mL and 10X Bacillus salts 9mL and keep them in the fridge, never use them twice to avoid contamination
Protocols
Making Bacillus competent
1- Grow one blank plate of Bacillus Subtilis (or several if you want to transform different strains) for 20 hours at 37ºC (plate been kept on the bench for several days would be better)
2- Inoculate about 12mL of medium with several colonies. Mix the contents of the tube. Check with OD650. Start OD should be between 0.1 and 0.2. Be careful to pipette 0.8mL of this mixture into the cuvette to measure and dispose of it after measurement to avoid contamination in the main mixture.
3- Incubate at 37ºC with vigorous shaking. Read the OD650 every 20min (never keep the solution you used for measuring!)
4- Plot log(OD650) in function of time. After a brief lag, you should observe a exponential increase. After awhile, it will leave the exponential growth; the moment at which it leaves the exponential path is denoted as t0 (3 on the graph). It should take about 100min and the OD should be between 0.35 and 0.55.

5- At t0, incubate for 90 minutes at 37ºC with vigorous shaking.
6- Transfer 0.05mL of this culture into 0.45mL of pre-warmed Medium B in an Eppendorf tube. You have to prepare one tube for each transformation, plus an extra tube for a DNA-less control.
7- Incubate the diluted cultures at 37ºC with shaking for 90min. At this moment, the cells are HIGHLY COMPETENT.
8- To check for competency, you can look at cells under the microscope; competent cells are very motile.
Transforming
1- Spin Eppendorf tubes containing cells. Remove 400µL of liquid to keep only 100µL of the culture (to concentrate cells). Re-suspend the cell pellet in the remaining culture.
2- To transform from competent glycerol stocks, spin the tube at about 1600rpm for 20min, remove the supernatant (glycerol), and add 100µL of pre-warmed medium B.
3- Mix the cells thoroughly.
4- Add 0.6µg of DNA to the competent cells.
5- Incubate for 30min at 37ºC with shaking.
6- Plate 100µL of transformed cells onto selective agar.
Glycerol stocks
1- To freeze competent Bacillus cells, spin down the fresh competent cells to obtain a pellet.
2- Remove all supernatant.
3- Re-suspend cells in 500µL 60% glycerol.
4- Freeze tubes at -80ºC.
Results
Transformation with episomal vectors
ECE166
- Selectable on Chloramphenicol 5µg/mL
- High-level constitutive expression of a Green Fluorescent Protein (with the promoter PupP)
We obtain consistent good results with this transformation despite low efficiency.


Transformation with integration vectors
ECE153
- Selectable on Spectinomycin 50µg/mL
- Transformation in IA751 : Amylase test
- Xylose-inducible promoter which allow to see fluorescence
Protocol of the amylase test
1- Prepare some blank agar plate
2- Dissolve 1g of starch into 100mL of soft agar, boil it to sterilise
3- Add a thin layer of soft agar (with starch) on blank plates
4- Put different single colonies on plate. You should do one positive control IA751 (degrades amylase), one negative control IA771 (does not degrade amylase), and a plate with your IA751 transformed with ECE153 (if they are transformed, they should not degrade amylase due to knockouts of the AmyE gene during transformation)
5- Incubate over night at 37ºC
6- Add 5mL of Gram’s Iodine stain
7- Incubate at room temperature for 1min
8- Decant the stain and observe the zones of clearing

Protocol of the xylose test
1- Incubate single colonies into different tubes of LB with antibiotic selection (Spc50) over night at 37ºC
2- Add 1mL of this culture, 8mL of LB, antibiotic (Spc50), and 1mL of xylose 0.1g/mL (to have a final concentration of 1%)
3- Incubate for 5 hours
4- Observe with microscope
We obtain good result for transformation. Amylase test is positive, but we have not manage to induce Pxyl.
ECE112
- Selectable on Chloramphenicol 5µg/mL
- Transformation in IA751 : Amylase test
